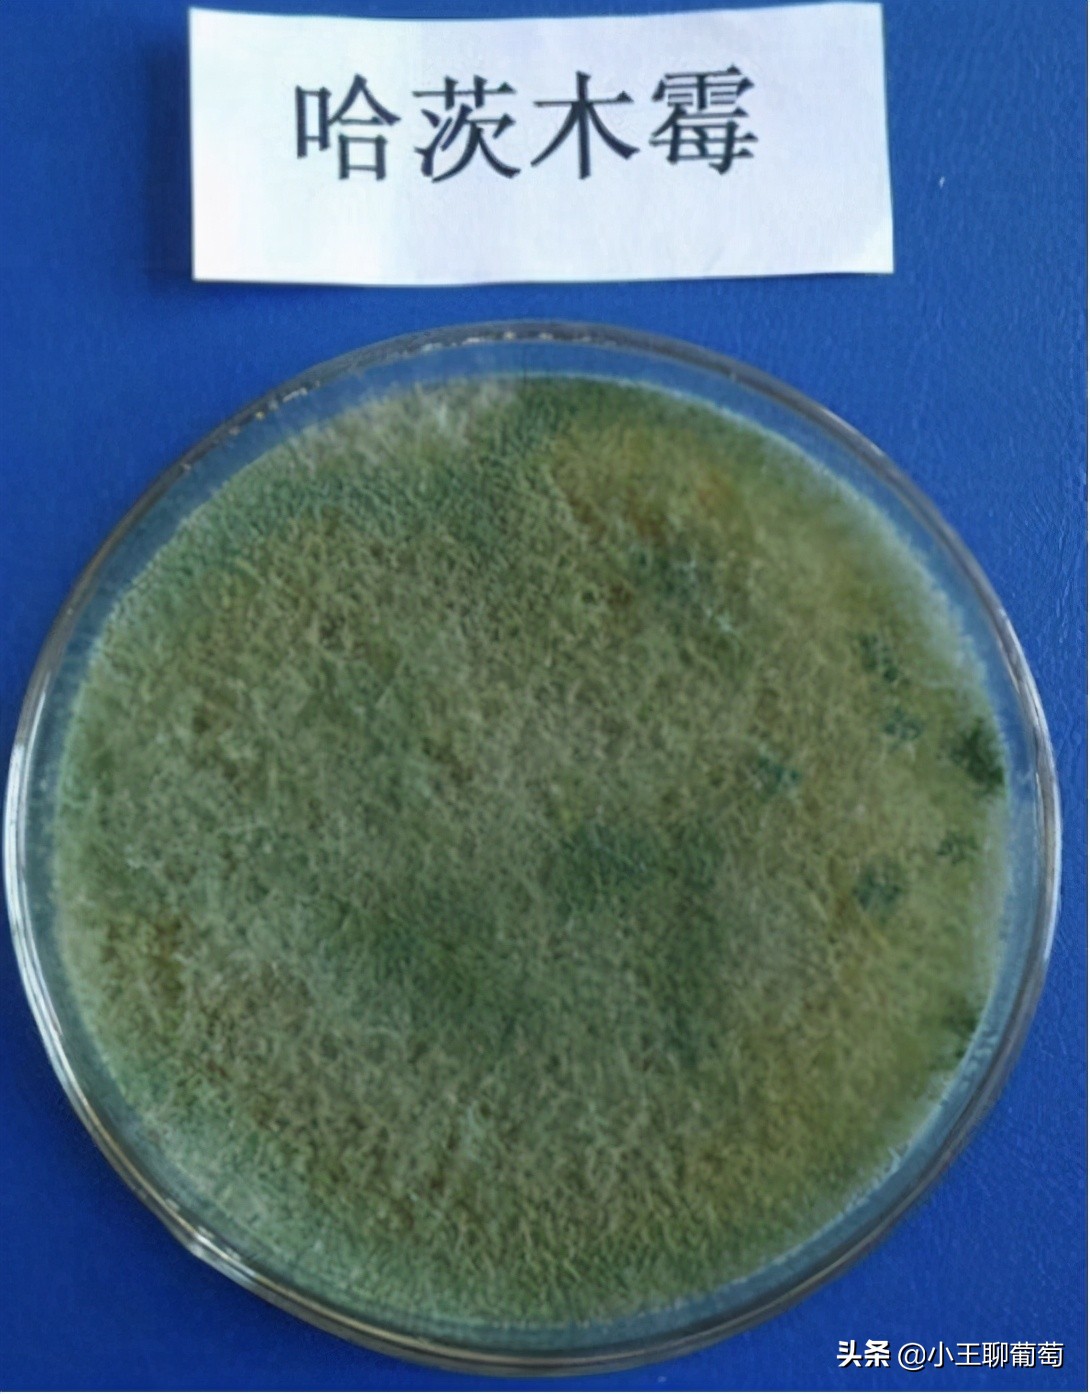
有病治病没病可以养根护根,有病治病没病杀菌
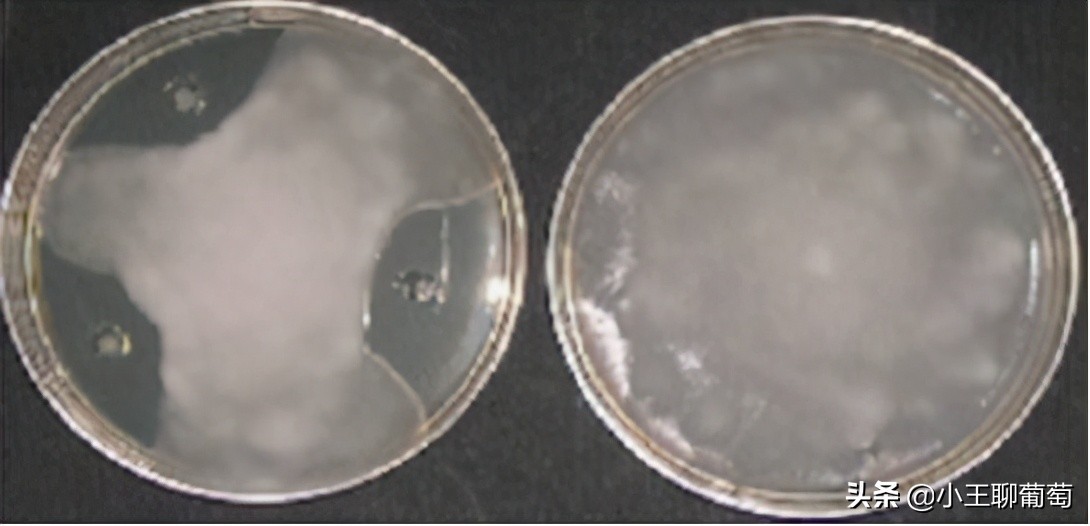
有病治病没病可以养根护根,有病治病没病杀菌
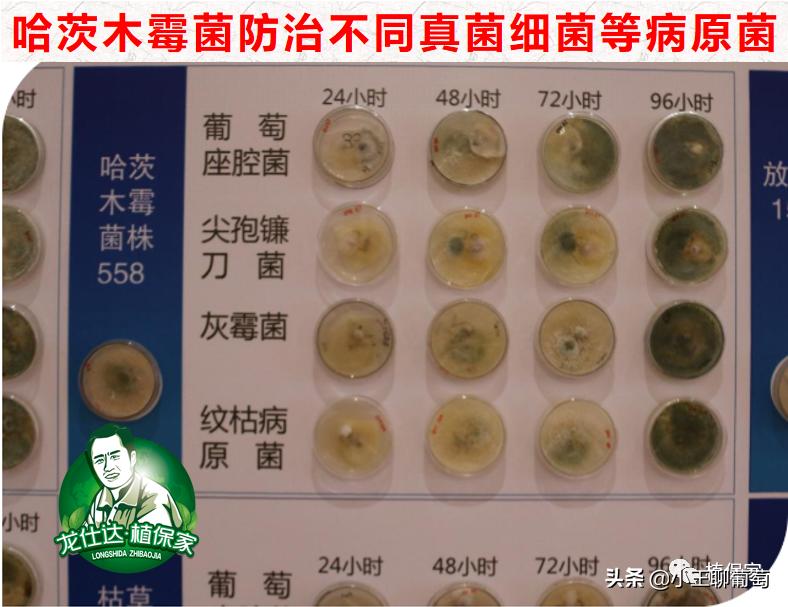
有病治病没病可以养根护根,有病治病没病杀菌

微生物菌主要 抑制病原菌能量产生、干扰生物合成和破坏细胞结构,内吸性强、毒性低,有的兼有刺激植物生长的作用 ,并且无公害、无污染、无残留、且不易产生抗药性等特点,近年在研发、登记和应用上都获得了长足的发展。

哈茨木霉菌
哈茨木霉菌对 土传病菌 包括:白绢病菌、立枯丝核菌、终极腐霉、核盘菌、尖子包镰刀菌、瓜果腐霉、大基点核菌、黑根霉、柱孢霉、核盘菌、齐整小核菌等; 叶部病原菌 包括灰葡萄球菌、灰葡萄孢菌、立枯丝核菌等
一、竞争作用: 哈茨木霉菌T-22在植物的 根围、叶围 可以迅速生长,抢占植物体表面的位点,形成一个保护罩,就像给植物穿上靴子一样, 阻止病原真菌接触到植物根系及叶片表面,以此来保护植物根部、叶部免受上述病原菌的侵染 ,并保证植株能够健康地成长。

二、重寄生作用: 重寄生作用是指 对病原菌的识别、接触、缠绕、穿透和寄生 一系列连续步骤的复杂过程。在木霉与病原菌互作的过程中,寄主菌丝分泌一些物质使木霉趋向寄主真菌生长, 一旦寄主被木霉寄生物所识别,就会建立寄生关系 。

木霉对寄主真菌识别后,木霉菌丝沿寄主菌丝平行生长和螺旋状缠绕生长,并产生附着胞状分枝吸附于寄主菌丝上,通过 分泌胞外酶溶解细胞壁,穿透寄主菌丝,吸取营养,进而将病原菌杀死 。

三、抗生素作用: 哈茨木霉菌可以分泌一部分抗生素,可以 抑制病原菌的生长定植 ,减轻病原菌的危害。
四、植物生长调节作用: 木霉菌在植物根系定殖并且产生刺激植物生长和诱导植物防御反应的化合物, 改善根系的微环境,增强植物的长势和抗病能力 ,提高作物的产量和收益。

五、诱导植物抗性、启动植物的防御反应
T-22可以代谢产生木聚糖酶,植物在木聚糖酶作用下,具有明显的防御反应, K+、H+、Ca2 +离子通道打开,合成乙烯以及积累PR蛋白等。 T-22产生几丁质酶和β-1 ,3-葡聚糖酶在抗植物病原真菌中发挥重要作用。

可以启动植物的防御反应,导致 植物产生和积累与抗病性有关的酚类化合物和木质素等。 同时T-22产生的蛋白酶能使消解植物细胞壁的病原菌降解,直接抑制病原菌萌发,使病原菌的酶钝化,阻止病原菌侵入植物细胞。

枯草芽孢杆菌

一、抗生作用
抗生作用是指微生物通过产生代谢产物在低浓度下就能够 对病原微生物的生长和代谢产生抑制作用 ,从而来影响病原微生物的生存和活动。
二、溶菌作用
枯草芽孢杆菌的溶菌作用主要表现在是通过 吸附在病原菌的菌丝上,并随着菌丝生长而生长 ,而后产生溶菌物质造成原生质泄露使得菌丝体断裂;或者是产生抗菌物质通过溶解病原菌孢子的细胞壁或细胞膜,致使细胞壁穿孔、畸形等现象从而抑制孢子萌发。

三、诱导植物产生抗性及促进植物生长
枯草芽孢杆菌不但能够抑制植物病原菌,而且 还能够诱 发植物自身抗病机制从而增强植物的抗病性能的作用,可以在植物根系周围形成PGPR。
什么是PGPR,国际上把土壤中能促进植物生长的根际自生细菌通称为植物促生根圈细菌 (Plantgrowth promoting rhizobaceria),简称为PGPR。
并且枯草芽孢杆菌 能够产生类似细胞分裂素、植物生长激素的物质,促进植物的生长使植物抵抗 病原菌的侵害。

目前枯草芽孢杆菌在我国农药登记的防治对象包括的 *粉白**病、霜露病、疫病、灰霉病、软腐病、叶枯病、纹枯病、青枯病、根腐病、溃疡病等多种真菌和细菌性病害。

本品利用尖端微囊技术 消除了菌群与菌群之间的拮抗作用 , 确保菌的活性与裂变和存活时间 , 精选优势土壤宜居菌种 ,使复合微生物菌群进行协同作用, 发挥不同菌种之间的优势,使复合微生物菌群迅速占位发挥作用,从而达到 以菌抑菌,以菌克菌,以菌治菌的效果。对所有真菌细菌病害都有效果,对根腐死棵土传病害特效! 被称为植物“保镖”,有病治病,没病健壮植物不生病!

(1)拌种: 将种子放入清水中浸湿后捞出控干,随后将本品撒在种子上,混拌均匀,阴干后播种。每50kg种子用药60-100g,。使用种衣剂的种子应先拌种衣剂,后拌本品,阴干后播种,随拌随播。
(2)拌土: 作种肥或底肥时,可将本品与潮土拌在一起,施在种子周围或均匀撒在本田,距种子根系越近越好。大田作物用量为400-500g/亩,经济作物500-800g。
(3)灌根: 配制成100g/100L的药液,每株浇灌200ml,根据植株的大小可以适当调节用量。

(4)叶面喷施: 300倍稀释后均匀喷雾,苗期可减半使用。
(5)蘸根: 对于移栽作物,将本品兑适量水,配制成50-100g/L的药液,然后蘸根或者球茎即可。
(6)拌肥: 作种肥或底肥时,可将本品与化肥或有机肥拌在一起,随肥料一起施用,须随拌随用,以免造成肥料融化而影响播肥质量。
(7)盆栽及苗床混土: 每立方米用药60-100克,根据用水量先配置成母液,然后混匀即可。
(8)苗床喷施: 每平方米用2-5g药剂,淋喷苗床上即可。